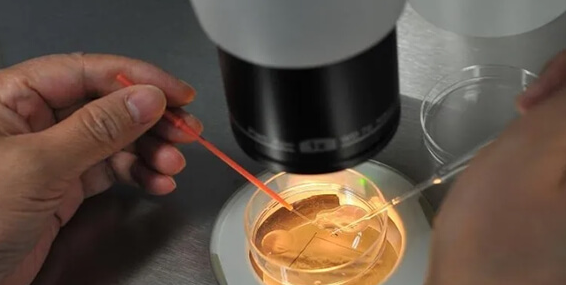

泰国试管婴儿技术凭借成熟的技术体系与高成功率,成为全球辅助生殖领域的热门选择。然而,移植成功率并非单一因素决定,而是多重变量共同作用的结果。除子宫内膜厚度外,以下八大核心因素直接影响胚胎着床与妊娠结局。
一、年龄:不可逆的生育时钟
女性年龄是影响成功率的首要因素。35岁以下女性卵巢功能处于黄金期,卵子质量高,染色体异常率低,移植成功率可达60%-80%;而40岁以上女性卵子染色体异常率骤增至90%,成功率显著下降。泰国生殖中心数据显示,35-40岁患者单周期成功率约40%-50%,40岁以上则不足30%。
二、卵巢储备功能:卵子数量的“储蓄罐”
卵巢储备功能通过AMH(抗缪勒管激素)值评估,反映剩余卵子数量与质量。AMH值越高,促排后获取优质卵子的概率越大。泰国医生常结合AMH与基础卵泡数(AFC)制定个性化促排方案,确保高效利用卵巢资源。
三、胚胎质量:生命起点的“质量关卡”
胚胎质量由卵子、精子及实验室技术共同决定。泰国采用PGT-A(三代试管技术)对胚胎进行染色体筛查,淘汰非整倍体胚胎,将移植成功率提升至70%以上。优质囊胚(如5AA级)的着床率是普通胚胎的2-3倍。
四、子宫内膜容受性:胚胎着床的“土壤条件”
除厚度(8-12mm为佳)外,子宫内膜血流、形态及激素环境同样关键。泰国医生通过超声评估血流阻力指数(RI),结合宫腔镜排除息肉、粘连等病变,必要时进行宫腔灌注治疗,改善内膜环境。
五、男方因素:精子质量的“隐形门槛”
精子DNA碎片率(DFI)超过30%会显著降低受精率与胚胎质量。泰国生殖中心对男方进行精液常规、DFI检测,对严重少弱精患者采用ICSI(单精子注射)技术,确保受精过程精准可控。
六、移植技术:精准操作的“最后一公里”
泰国医生通过超声引导将胚胎放置于子宫内膜最佳着床点(通常为宫腔中上部),避免损伤血管或肌层。部分诊所采用ERA(子宫内膜容受性分析)技术,精准定位移植窗口期,将成功率提升15%-20%。
七、心理状态:内分泌平衡的“调节器”
焦虑、抑郁等负面情绪会通过下丘脑-垂体轴影响激素分泌,导致子宫内膜容受性下降。泰国生殖中心配备专业心理咨询师,通过认知行为疗法帮助患者缓解压力,提高治疗依从性。
八、医疗条件:技术设备的“硬实力支撑”
泰国顶尖生殖中心配备Time-lapse胚胎培养箱、激光辅助孵化仪等先进设备,实现胚胎发育全程动态监测。经验丰富的胚胎师团队通过形态学评估与AI算法,精准筛选最具发育潜力的胚胎。
泰国试管移植成功率是医学技术、个体条件与心理因素综合作用的结果。患者需在术前进行全面评估,选择具备PGT技术与个性化诊疗方案的正规机构,同时保持积极心态,才能最大化提升成功概率。








